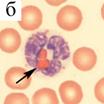

На правах рукописи
![]()
КИЖИНА
Александра Геннадьевна
МОРФОФУНКЦИОНАЛЬНЫЕ ОСОБЕННОСТИ
ЛЕЙКОЦИТОВ КРОВИ И КОСТНОГО МОЗГА
НОРОК (Mustela vison Schr.)
03.03.01 – физиология
Автореферат
диссертации на соискание ученой степени
кандидата биологических наук
Петрозаводск – 2011
Работа выполнена в лаборатории экологической физиологии животных Учреждения Российской академии наук Институте биологии Карельского научного центра РАН (ИБ КарНЦ РАН)
Научный руководитель: доктор сельскохозяйственных наук,
профессор, заслуженный деятель науки РК
Официальные оппоненты: доктор биологических наук
доктор ветеринарных наук, профессор
Ведущая организация: ФГОУ ВПО Московская государственная академия ветеринарной медицины и биотехнологии имени
Защита состоится «24» ноября 2011 года в 15 часов на заседании диссертационного совета ДМ 212.087.02 при Карельской государственной педагогической академии Республика Карелия, г. Петрозаводск, .
С диссертацией можно ознакомиться в библиотеке Карельской государственной педагогической академии.
Автореферат разослан « » октября 2011 г.
Ученый секретарь
Диссертационного совета,
кандидат медицинских наук, доцент
ОБЩАЯ ХАРАКТЕРИСТИКА РАБОТЫ
Актуальность темы. Лейкоциты играют существенную роль в защите организма, являясь основными фагоцитирующими клетками, участвуют в развитии воспаления и аллергических реакциях, выполняют секреторно-регуляторную функцию, влияют на процессы свертывания и фибринолиза (Бережная, 1988; Козинец и др., 2001; Маянский, Маянский, 1989; Фрейдлин, 1998). Они имеют огромное значение в регуляции гомеостаза и поддержании резистентности организма к действиям факторов среды (Гаркави, Квакина, Уколова, 1990). Поэтому исследование физиологии лейкоцитов является важным в изучении таких проблем биологии, как адаптация и устойчивость организма. Несмотря на значительный период, прошедший после разработки учения о фагоцитозе, в настоящее время лейкоциты служат объектом широкого круга исследований по физиологии и иммунологии человека и животных. Большинство из них посвящено изучению лейкоцитов человека и лабораторных животных при различных физиологических и патологических состояниях. Изучение морфофункциональных свойств лейкоцитов и изменения их в онтогенезе у животных, как разводимых в неволе, так и из природных популяций освещено недостаточно полно и требует дополнительных исследований.
Особый интерес представляют исследования лейкоцитов у одного из представителей хищных млекопитающих – американской норки (Mustela vison Schreber, 1777), введенной в зоокультуру. В условиях промышленного разведения у этого вида животных зарегистрирована высокая частота появления доминантных и полудоминантных мутаций окраски волосяного покрова, которые, за редким исключением, не наблюдались до периода разведения в неволе. Мутации обладают плейотропным действием и носят системный характер (Трапезов, Трапезова, 2009). Норки различных генотипов отличаются от исходного типа и между собой физиологическими особенностями: размерами тела и внутренних органов, уровнем метаболизма, скоростью развития в онтогенезе и репродуктивной функцией (Беляев, Исакова, Назарова, 1981; Вагин, 2003; Ильина, Кузнецов, 1983; Колдаева, Колдаев, 2007). Некоторые породы норок, разводимые в звероводческих хозяйствах, характеризуются низкими показателями жизнеспособности и высокой чувствительностью к заболеваниям. К ним относятся норки, в генотипе которых присутствует ген алеутской окраски (а/а). Уникальность этих пород норок состоит в том, что в связи с морфофункциональным дефектом лейкоцитов, они могут быть моделью редкого генетического заболевания человека – синдрома Чедиак-Хигаши (СЧХ). Согласно литературным данным, функциональная активность лейкоцитов при СЧХ улучшается под влиянием витамина С, обладающего иммуностимулирующими и антиоксидантными свойствами (Oliver, Zurier, 1976; Weening et al., 1981). В доступной нам литературе данные экспериментальных исследований по изучению аналогов СЧХ у пушных зверей, разводимых в неволе, крайне малочисленны.
В связи с этим очевидна актуальность исследования морфофункциональных свойств лейкоцитов у темно-коричневых норок, близких к дикому типу, серебристо-голубых, сапфировых и других окрасов, имеющих генетический дефект, а также способов его коррекции.
Работа выполнена при финансовой поддержке грантов Президента РФ НШ – 4310.2006.4, НШ – 306.2008.4 и НШ – 3731.2010.4, ФЦП ГК № 02.740.11.0700 и в рамках сотрудничества между Польской академией наук и Российской академией наук, проект № 65.
Цель и задачи исследования. Целью настоящей работы являлось изучение морфофункциональных особенностей лейкоцитов периферической крови и костного мозга у норок различных цветовых окрасов в постнатальном онтогенезе.
Для достижения цели были поставлены следующие задачи:
1. Определить содержание лейкоцитов, состав лейкоцитарной формулы крови у стандартных темно-коричневых, серебристо-голубых и сапфировых норок в постнатальном онтогенезе.
2. Исследовать морфофункциональные особенности лейкоцитов – морфологические и морфометрические параметры внутриклеточных гранул, локализацию и активность пероксидазы, нафтол-AS-D-хлорацетат эстеразы (НХЭ) и щелочной фосфатазы (ЩФ) у стандартных темно-коричневых, серебристо-голубых и сапфировых норок в постнатальном онтогенезе.
3. Изучить возрастные особенности гранулогенеза в лейкоцитах костного мозга у стандартных темно-коричневых, серебристо-голубых и сапфировых норок в процессе клеточной дифференцировки.
4. Исследовать морфологию и структуру лейкоцитов у норок различных цветовых окрасов.
5. Оценить влияние иммуностимулятора – витамина С на морфофункциональные особенности и состав лейкоцитов крови у стандартных темно-коричневых и сапфировых норок.
Научная новизна. Впервые с использованием морфометрических и цитохимических методов проведено детальное сравнительное исследование морфофункциональных свойств лейкоцитов у норок стандартного темно-коричневого, серебристо-голубого и сапфирового окрасов. Показано, что норки исследованных генотипов различаются между собой по содержанию и составу лейкоцитов крови, морфометрическим параметрам гранул, активности и локализации ферментов (пероксидаза, НХЭ, альфа-нафтилацетат эстераза) и других соединений (гликоген, бактерицидный протеин) в лейкоцитах. Аномальные гранулы в лейкоцитах сапфировой норки формируются на ранних этапах созревания клеток в костном мозге и имеют лизосомальное происхождение. Выраженность дефекта лейкоцитов усиливается в ходе клеточной дифференцировки в костном мозге и в постнатальном онтогенезе. Показано, что дефект связан с алеутским геном (a/a) и модифицируется генетическим окружением.
Научно-практическое значение работы. Результаты данного исследования расширяют представление о морфофункциональных особенностях и роли лейкоцитов в механизмах устойчивости. Полученные данные могут применяться в качестве возрастной нормы у норок стандартного темно-коричневого, серебристо-голубого и сапфирового окрасов, а также для оценки и изучения влияния на организм разнообразных факторов – биологически активных добавок, вакцинации, стресса и различного типа патологий, а также для оздоровления клеточной популяции норок. Выявление аномальных гранул может быть использовано для подтверждения алеутского гена в генотипе мутантных норок и обнаружения подобных аномалий у других видов пушных зверей. Увеличение содержания лейкоцитов периферической крови сапфировых норок при применении витамина С дает основание рекомендовать его к использованию в рационах животных этого окраса при угнетении лейкопоэза.
Апробация работы. Основные положения диссертационной работы представлены на 3-м Международном симпозиуме «Физиологические основы повышения продуктивности млекопитающих, введенных в зоокультуру» (Петрозаводск, 2005), расширенном заседании Отделения биологических наук РАН (Петрозаводск, 2006), 10-й Международной Пущинской школе-конференции молодых ученых «Биология – наука XXI века» (Пущино, 2006), Российской конференции молодых сотрудников и аспирантов ИПЭЭ им. (Москва, 2008), 15-ой школе «Актуальные проблемы биологии развития» (Звенигород, 2008), 4-м Международном симпозиуме «Современные проблемы и методы экологической физиологии и патологии млекопитающих, введенных в зоокультуру» (Петрозаводск, 2009), Международной научно-практической конференции, посвященной 80-летию Вятской государственной с.-х. академии и 45-летию подготовки биологов-охотоведов (Киров, 2010), 21-м съезде физиологического общества им. (Калуга, 2010), International scientific conference «Scientific achievements and the breeding practice» (Krakow, 2010).
Положения, выносимые на защиту:
1. Морфофункциональные особенности лейкоцитов крови и костного мозга норок зависят от генотипической принадлежности животного и периода постнатального онтогенеза.
2. Норки сапфирового окраса имеют наследственный дефект лейкоцитов. Аномальные структуры принадлежат к первичным гранулам нейтрофилов и к специфическим эозинофилов. Дефект формируется в костном мозге и усиливается в ходе клеточной дифференцировки.
Публикации. По теме диссертации опубликовано 29 научных работ из них 7 статей в Российских рецензируемых журналах, рекомендованных ВАК РФ и 1 методическое руководство.
Объем и структура работы. Диссертация изложена на 160 страницах машинописного текста, содержит 5 таблиц и 34 рисунков. Работа состоит из введения, обзора литературы, описания материалов и методов исследования, 5 глав результатов собственных исследований, обсуждения, заключения, выводов и списка литературы, который включает 344 наименований, из них 156 иностранных.
Благодарности. Выражаю глубокую и искреннюю признательность к. б.н. за всестороннюю помощь и поддержку, научному руководителю д. с.-х. н. и заведующему лабораторией экологической физиологии животных, д. б.н. за ценные советы и рекомендации при подготовке диссертации. Выражаю благодарность всем сотрудникам лаборатории за активную помощь и конструктивные замечания. Благодарю коллектив , а также к. б.н., заведующего сектором генетики куньих Института цитологии и генетики СО РАН за сотрудничество и помощь при сборе биологического материала. Отдельная благодарность студентам биологического факультета Петр ГУ , , за техническую помощь при сборе материала.
Материалы и методы исследования
Объекты исследования. Объектами исследования служили американские норки (Mustela vison Schreber, 1777, сем. Mustelidae, отр. Carnivora) различных окрасов: стандартные темно-коричневые (+/+), монорецессивные серебристо-голубые (p/p) и дирецессивные сапфировые (a/a p/p). Исследование лейкоцитов крови проводилось у 4-, 10-, 60-, 120-, 180-дневных норок по 5-8 особей, и у взрослых по 12 особей, костного мозга – у 4-, 10-, и 180-дневных норок по 5-6 особей каждого окраса. Экспериментальные животные содержались в стандартных условиях на звероводческой ферме (Республика Карелия).
Кроме того, в осенний период производилось взятие крови у норок из коллекции окрасочных генотипов, содержащихся на экспериментальной звероферме Института цитологии и генетики СО РАН (г. Новосибирск). В исследовании использовались норки 14 генотипов: монорецессивные – алеутские (a/a), белые-хедлунд (h/h); дирецессивные – лавандовые (m/m a/a), жемчужные (k/k p/p), финский топаз (tS/ tS b/b); трехрецессивные – виолет (m/m a/a p/p); комбинативные доминантно-рецессивные – Крестовка сапфир (S/+ a/a p/p), Сапфировый леопард (SK/+ a/a p/p) и Шéдоу-сапфир (SH/+ a/a p/p), Снежный топаз (CR /+ tS/tS b/b) и Куйтежская пёстрая (SK/+ b/b); полудоминантные из серии множественных аллелей «крестовка» Королевская серебристая (SR /+) и Стандартный леопард (SK/+); полудоминантные Чёрный хрусталь (CR /+). Животные были шестимесячного возраста, каждый окрас был представлен одной особью.
Забор крови и костного мозга производился у животных утром натощак. Для приготовления мазков кровь получали из хвостовой вены, а костный мозг из эпифиза бедренной кости. Мазки крови и костного мозга готовили по общепринятой методике (Мейер, Харви, 2007; Луговская и др., 2007).
Всего было исследовано 187 животных.
Методы исследования. Гематологическая окраска мазков осуществлена по методу Паппенгейма (Справочник…, 1975). Микрофотографии клеток крови и костного мозга получали в световом микроскопе Axioscop 40 (Zeiss) с цветной цифровой видеокамерой при помощи компьютерной системы анализа изображений и программного обеспечения “Видеотест-Морфология 4.0”. Содержание лейкоцитов определяли в день взятия по общепринятой методике (Берестов, 1971).
Для выявления пероксидазы, ЩФ, НХЭ препараты фиксировали 10%-ным раствором формалина в этиловом спирте в течении 30 с, для гликогена – 30 мин. Для определения альфа-нафтилацетат эстеразы фиксатором служили пары формалина (4 мин), для бактерицидного протеина – 5%-ный водный раствор сульфосалициловой кислоты (90 с). Для выявления пероксидазы фиксированные препараты помещали в инкубационную среду с орто-толидином на 7 мин. (Хейхоу, Кваглино, 1983). Определение активности ЩФ в лейкоцитах проводили с применением субстрата нафтол-АС-фосфата, растворенного в трис-HCl буфере (pH 9,0-9,2) в присутствии ионов Mg+ (Берстон, 1965). Альфа-нафтилацет эстеразу выявляли, используя альфа-нафтилацетат и фосфатный буфер (pH 7,8-8,0) (Леффлер, 1961), НХЭ с нафтил AS-D-хлорацетатом в фосфатном буфере (pH 7,2-7,4) (Буйкис, Руденс, 1972). Во всех трех случаях красителем служил прочный синий ВВ. Определение бактерицидного протеина проводили с использованием раствора бромфенолового синего в боратном буфере (pH 8,2) (Шубич, 1974). Гликоген выявляли ШИК-реакцией (реактив Шиффа – йодная кислота), красящим веществом в которой являлся фуксин (Обозная, Панков, 1989). В качестве ядерного красителя использовали приготовленный раствор гематоксилина.
Морфометрические параметры клеток и внутриклеточных гранул (количество, площадь, суммарная площадь), а также оптическую плотность измеряли с применением компьютерной методики NCR (nuclear cell relation), входящей в пакет программ «Видеотест-Морфология 4.0». Активность фермента определяли показателем, представляющим произведение суммарной площади продукта цитохимической реакции и оптической плотности (Славинский, 2000).
Исследование влияние витамина С на морфофункциональные особенности лейкоцитов крови проведено у шестимесячных норок стандартного темно-коричневого (n=8) и сапфирового (n=4) окрасов при равном соотношении полов. Опытная группа получала с кормом 100 мг витамина С на животное в течение 20 суток. Контролем служили звери, содержащиеся на общехозяйственном рационе без добавления препарата.
Полученные данные обрабатывались с использованием пакетов программ MS Exel и Statgraphics общепринятыми методами вариационной статистики. Оценку достоверности статистических показателей выборок проводили с применением непараметрического критерия Вилкоксона-Манна-Уитни и критерия Стьюдента (Коросов, Горбач, 2007).
Результаты исследования
Морфофункциональные особенности лейкоцитов крови у норок различных генотипов в постнатальном онтогенезе
Полученные результаты показывают, что в онтогенезе темно-коричневых, серебристо-голубых и сапфировых норок происходят значительные изменения содержания и состава лейкоцитов (Рис. 1, 2). В раннем постнатальном онтогенезе (4, 10 дней) выявлен пониженный уровень лейкоцитов у норок всех генотипов по сравнению с последующими периодами. Относительное низкое содержание лейкоцитов в первые дни жизни являются особенностью для многих видов млекопитающих (Новожилов, Катюхин, 2008; Jull-Madsen et al., 2010; Zelnickova et al., 2006).
|
Рис.1 Содержание лейкоцитов (M±m) в периферической крови у норок в постнатальном онтогенезе Условные обозначения здесь и на Рис. 7: цифры сверху столбиков – различия достоверны по сравнению с предыдущим возрастом, * – с темно-коричневыми, ◊ – с серебристо-голубыми норками, критерий Вилкоксона–Манна–Уитни (p<0,05). |
Период раннего онтогенеза отличается более низким количеством лимфоцитов и эозинофилов крови, а также повышенным содержание незрелых форм клеток: юных (мета-миелоцитов), палочкоядерных нейтрофилов и предшественников эритроцитов (ядросодержащих нормобластов) по сравнению с последующими периодами. Наибольшее количество незрелых форменных элементов содержалось в крови сапфировых норок, имеющих по сравнению с темно-коричневыми и серебристо-голубыми более низкую массу тела в этот период. Выявленные особенности клеточного состава крови возможно связаны с преобладанием эритропоэтинов над поэтинами агранулоцитов (Новожилов, Катюхин, 2008), расходами пула лимфоидных клеток на выполнение их трефоцитной функции (регуляция роста различных органов) (Fidler, 1980), изменением состояния костномозгового барьера вследствие перенесенной родовой гипоксии (Торубарова, Кошель, Яцык, 1993).
Максимальное содержание лейкоцитов крови выявлено у норок в 60-дневном возрасте и соответствует периоду усиленного роста, который требует соответствующего прироста количества клеток крови. Возрастание содержания лейкоцитов происходит за счет увеличения количества нейтрофилов, лимфоцитов и эозинофилов.
В дальнейшем в ходе индивидуального развития различия в содержании различных типов и общем количестве лейкоцитов между щенками и взрослыми животными всех трех генотипов заметно сокращаются. В целом нейтрофильное звено у темно-коричневых норок более выражено, чем у мутантных норок – серебристо-голубых и сапфировых.
|
Рис. 2. Состав лейкоцитарной формулы у норок в постнатальном онтогенезе |
В результате исследования обнаружены существенные генотипические различия в субклеточной структуре лейкоцитов. Установлено, что лейкоциты крови стандартных и серебристо-голубых норок имеют сходство по морфологическим признакам между собой и с лейкоцитами большинства видов млекопитающих. У сапфировых норок они обладают рядом особенностей. Во всех базофилах, эозинофилах, в части нейтрофилов, некоторых лимфоцитах и редко в моноцитах наблюдаются сильно увеличенные в размерах цитоплазматические гранулы (Рис. 3). Подобная аномалия выявлена в меланоцитах сапфировых норок, пигментные гранулы которых значительно превышали размер меланосом темно-коричневых и серебристо-голубых (Зверева, Беляев, 1976).
«Гигантские» внутриклеточные структуры имеют сходство с дефектом гранулярного аппарата при СЧХ человека. Клеточная патология значительно снижает активность лейкоцитов: ослабляет хемотаксический ответ и фагоцитарную способность нейтрофилов и макрофагов, нарушает функционирование естественных киллеров и цитотоксических Т-лимфоцитов (Introne, Boissy, Gahl, 1999; Kaplan, De Domenico, McVey Ward, 2008; Roder, Duwe, 1979). Согласно современным данным клеточный дефект связан с нарушением везикулярного транспорта, приводящего к появлению аномальных структур в клетках различных органов и тканей (Huizing et al., 2008; McVey Ward et al., 2000). Аномалия лейкоцитов у сапфировых норок, вероятно, является одной из причин снижения резистентности по отношению к различным заболеваниям, в частности к алеутской болезни.

Рис. 3. Сегментоядерные нейтрофил (а), эозинофил (б), базофил (в) и лимфоцит (г) крови сапфировой норки
Аномальные гранулы отмечены стрелками. Здесь и на Рис. 5. окраска по Паппенгейму, масляная иммерсия, Об. 100, ок. 10, масштаб 10 мкм.
Дефект лейкоцитов у сапфировых норок особенно сильно выражен в эозинофилах: количество гранул и средняя площадь одной гранулы в клетке равняются 12,36±1,06 шт. и 1,21±0,07 мкм2, соответственно, тогда как у темно-коричневых составляют 116,8±9,44 шт. и 0,13±0,00 мкм2, соответственно. Аномальные формы лейкоцитов присутствуют в крови норок во все возрастные периоды, но выраженность дефекта в постнатальном периоде онтогенеза изменяется – содержание аномальных форм лимфоцитов и сегментоядерных нейтрофилов увеличивается с возрастом.
Степень дефекта в лейкоцитах в ходе онтогенеза повышается – максимальный размер и наибольшая вариабельность площади гранулы в нейтрофилах имеют 180-дневные и взрослые животные, а в эозинофилах – норки старше 60 дней (Рис. 4).
Таким образом, в онтогенезе у норок происходят значительные изменения содержания, состава и морфофункциональных свойств лейкоцитов периферической крови. Щенки норок в раннем постнатальном онтогенезе демонстрируют незрелость гемопоэтической системы, темпы развития которой определяются генотипом животных. Высокий уровень нейтрофильных гранулоцитов у норок в раннем постнатальном онтогенезе свидетельствует о важной роли неспецифических защитных механизмов, тогда как низкие значения содержания лимфоцитов и эозинофилов указывают на слабое развитие антипаразитарного и специфического иммунитета. Обнаруженный у сапфировых норок дефект лейкоцитов усиливается в ходе постнатального онтогенеза.
|
Рис. 4. Количество (А), площадь (Б) гранул эозинофилов и сегментоядерных нейтрофилов у норок сапфирового окраса в постнатальном онтогенезе. Представлены средние значения (столбики), моды (точки) и границы колебаний Условные обозначения: цифры сверху столбиков – различия достоверны по сравнению с предыдущим возрастом, критерий Вилкоксона–Манна–Уитни (p<0,05). |
Морфофункциональные особенности лейкоцитов костного мозга у норок различных генотипов в постнатальном онтогенезе
Клеточный состав костного мозга темно-коричневых, серебристо-голубых и сапфировых норок в основном представлен элементами гранулоцитарного, эритроцитарного и мегакариоцитарного рядов различных стадий созревания.
У стандартных и серебристо-голубых норок гранулоциты костного мозга на всех этапах клеточного цикла имеют морфологию, типичную для большинства млекопитающих. Зрелые нейтрофилы и их предшественники у стандартных и серебристо-голубых норок имеют едва заметную зернистость, а эозинофилы – относительно крупные специфические гранулы (Рис. 5 а-г). Структурно-морфологических различий на светомикроскопическом уровне в ранних и зрелых нейтрофилах и эозинофилах между стандартными и серебристо-голубыми норками не выявлено. Лейкоциты у щенков норок этих генотипов в раннем онтогенезе имеют те же морфологические особенности (размеры клеток, форма ядра, характер зернистости окраска цитоплазмы), что и клетки более взрослых животных.
Возрастные различия заключаются в сниженном количестве эозинофильных лейкоцитов у 4- и 10-дневных щенков по сравнению с 180-дневными и повышенном содержании предшественников эритроцитов (нормобластов), которое является подтверждением активного эритропоэза в ранний постнатальный период онтогенеза.




Рис. 5. Эозинофильные миелоцит (а, д) и метамиелоцит (б, е), палочкоядерный (в, ж) и сегментоядерный (г, з) эозинофилы костного мозга темно-коричневой (а-г) и сапфировой (д-з) норок. Эозинофильные лейкоциты отмечены стрелками
У сапфировых норок в лейкоцитах костного мозга происходит нарушение формирования гранул, приводящее к появлению аномальных клеточных структур (Рис. 5 д-з). Обнаружено, что у норок этого окраса внутриклеточный дефект присутствует в гранулоцитах костного мозга и отсутствуют в других типах лейкоцитов. Дефектные структуры, образующиеся в процессе слияния гранул друг с другом, выявлены на ранних стадиях созревания (промиелоцит), когда образуются первичные гранулы в нейтрофильных лейкоцитах и специфические – в эозинофильных. В нейтрофилах «гигантские» гранулы отчетливо видны в миелоцитах, тогда как в эозинофилах наиболее крупные структуры встречаются на более поздних стадиях созревания – в зрелых клетках. Выявленные различия, вероятно, связаны с функциональными особенностями этих типов гранулоцитов и временем прохождения отдельных стадий в процессе клеточной дифференцировки.
|
Рис. 6. Площадь гранулы (M±m) в эозинофильных миелоцитах (Мэ), метамиелоцитах (Юэ), палочкоядерных (Пэ) и зрелых эозинофилах (Экм) костного мозга и периферической крови (Эк) у 10-, 180-дневных норок сапфирового окраса Условные обозначения: сверху столбиков Мэ, Юэ, Пэ, Экм, Эк – различия достоверны по сравнению с предыдущей стадией развития клетки (p<0,05); по сравнению с 10-дневными животными * – p<0,05, ** – p<0,01, критерий Вилкоксона–Манна–Уитни. |
Особенно демонстративны изменения количества, величины, формы гранул, происходящие в эозинофилах. Образование увеличенных гранул в эозинофилах сопровождается уменьшением их количества по мере развития клетки (Рис. 6). Это может быть связано с распределением их в ходе митоза в лейкоцитах пролиферирующего пула и за счет слияния в конгломераты. Полученные данные согласуются с электронномикроскопическими исследованиями, указывающими, что нарушения нарастают в ходе развития клеток (Davis et al., 1971). Нашими исследованиями показано, что степень выраженности дефекта на всех стадиях развития эозинофилов по величине аномальных гранул у молодых щенков значительно ниже, чем у норок более зрелого возраста (Рис. 6).
Таким образом, у норок в клеточном составе костного мозга выявлены существенные возрастные различия, а также генотипические особенности в субклеточной организации лейкоцитов. У сапфировых норок в лейкоцитах дефект гранул формируется на ранних стадиях развития клетки, усиливается в ходе клеточной дифференцировки в костном мозге, а также в постнатальном онтогенезе животного.
Цитохимическая характеристика лейкоцитов крови у норок
различных генотипов
В оценке функциональных свойств лейкоцитов большое значение имеет исследование содержания ферментов (Славинский, 2008). Пероксидаза и НХЭ, локализующиеся в первичных гранулах нейтрофилов, участвуют в фагоцитарной функции (Славинский, Никитина, 2000 а, б). ЩФ как компонент мембран секреторных гранул была обнаружена в нейтрофилах крови у человека (Borregaard, Cowland, 1997), по некоторым данным она наблюдается в эозинофилах и базофилах (Шубич, Нагоев, 1980). ЩФ принадлежит значительная роль в клеточном метаболизме, в связи с участием в обмене углеводов, фосфолипидов, нуклеиновых кислот (Шубич, Нагоев, 1980).
В локализации ферментов в лейкоцитах крови норок – пероксидазы, НХЭ и ЩФ установлены существенные генотипические различия. У темно-коричневых и серебристо-голубых норок продукт цитохимической реакции на пероксидазу, НХЭ и ЩФ равномерно распределен в лейкоцитах. У сапфировой норки пероксидаза и НХЭ локализуются в крупных структурах, соответствующих аномальным гранулам. В дефектных гранулах лейкоцитов также содержались лизосомальный фермент – альфа-нафтилацетат эстераза, бактерецидный протеин и отсутствовали ЩФ и гликоген. Распределение ферментов в лейкоцитах сапфировых норок свидетельствует о том, что дефектные структуры являются в нейтрофилах первичными гранулами (лизосомами), а в эозинофилах специфическими.
Активность ферментов в лейкоцитах у норок изменяется с возрастом. Так, активность пероксидазы в большинстве случаев в раннем онтогенезе была ниже по сравнению с взрослыми норками (Рис. 7 А). Сниженный уровень активности пероксидазы наблюдается у 4-дневных темно-коричневых и сапфировых норок, тогда как у серебристо-голубых, обладающих наибольшей жизнеспособностью, она выше. Более низкую активность пероксидазы у животных в раннем постнатальном онтогенезе и увеличение ее с возрастом отмечалась и для других видов млекопитающих (Инюкина, Гугушвили, 2009; Corberand et al., 1973; Ferencik et al., 1975).
Высокий уровень активности некоторых лизосомальных гидролаз в раннем постнатальном онтогенезе обусловлено характерной для этого периода перестройкой метаболизма и обновлением клеточных структур (Покровский, Тутельян, 1976). В этот период наиболее высокая активность НХЭ выявлена в нейтрофилах щенков сапфировых норок, что, возможно, связано с деструкцией дефектных клеточных структур (Рис. 7 Б). При СЧХ у человека и СЧХ-подобном заболевании у животных процесс выделения ферментов и особенно пероксидазы в фагоцитарную вакуоль нарушен (Root, Rosenthal, Balestra, 1972). Несмотря на относительно высокую активность ферментов в отдельные периоды постнатального онтогенеза у сапфировых норок, эффективность их функционирования, по всей видимости, значительно снижена, что, вероятно, является одной из причин ослабления защитных реакций организма.
|
Рис. 7. Активность пероксидазы (А), нафтол-AS-D-хлорацетат эстеразы (Б) и щелочной фосфатазы в лейкоцитах (В) у норок в постнатальном онтогенезе Условные обозначения те же, что и на Рис. 1 |
Реакция на ЩФ относится к наиболее чувствительным цитохимическим тестам, ее интенсивность может меняться при ряде физиологических и патологических состояний (Шубич, Нагоев, 1980). Установлено что норкам, как и другим видам хищных пушных зверей, в отличие от большинства растительноядных видов, свойственен низкий уровень лейкоцитарной фосфатазы. По нашим данным ЩФ норок обнаруживается преимущественно в эозинофилах. Наибольшая активность отмечена у щенков норок 4- и 60-дневного возраста (Рис. 7 В). По данным и (1981) максимальная активность ЩФ в сыворотке крови норок зарегистрирована на 60 день постнатального онтогенеза, что, по-видимому, связано с интенсивно идущими процессами роста и кальцификацией костной ткани. В лейкоцитах увеличение активности ЩФ наблюдается во время активного роста, а также у самок в репродуктивный период – беременность и лактацию (Узенбаева и др., 2000).
Таким образом, активность пероксидазы, НХЭ, ЩФ в лейкоцитах норок изменяется с возрастом. Анализ локализации ферментов в лейкоцитах сапфировых норок указывает, что дефектные клеточные структуры, содержащие пероксидазу, НХЭ, бактерицидный протеин, альфа-нафтилацет эстеразу соответствуют аномальным лизосомам.
Влияние генов окраски меха на морфофункциональные
особенности лейкоцитов крови
Аномалия первичных гранул лейкоцитов выявлена не только у сапфировых норок, но и у других пород норок, в генотипе которых присутствует ген алеутского окраса (a/a): алеутская, лавандовая, виолет, крестовка сапфир, Сапфировый леопард и Шедоу-сапфир. В то же время изменений клеточной структуры не наблюдалась у норок окрасок: стандартная темно-коричневая, серебристо-голубая, белая-хедлюнд, жемчужная, финский топаз, Снежный топаз и Куйтежская пёстрая, Королевская серебристая, Стандартный леопард и Чёрный хрусталь, в генотипе которых алеутский ген (a/a) отсутствует. Данные, полученные на норках различных генотипов, свидетельствуют, что на процесс формирования видоизмененных цитоплазматических структур влияет мутация в локусе (a/a). Среди норок с геном алеутского окраса обнаружены различия в содержании аномальных форм лейкоцитов, морфологии и количестве патологических гранул.
Таким образом, морфофункциональный дефект лейкоцитов у норок различных генотипов связан с алеутским геном. Генетическое окружение, затрагивающее пигментацию, определяет выраженность дефекта лейкоцитов.
Влияние витамина С на морфофункциональные особенности лейкоцитов крови у норок различных генотипов
|
Рис. 8. Влияние витамина С на абсолютное содержание различных типов лейкоцитов в крови норок Условные обозначения: к – контроль, о – опыт, м – моноциты, лф – лимфоциты, пн – палочкоядерные и сн – сегментоядерные нейтрофилы, э– эозинофилы, б – базофилы. * – различия в общем количестве и ^ – количестве аномальных лейкоцитов достоверны по сравнению с контрольной группой, ◊ – по сравнению с темно-коричневыми норками (p<0,05). |
Влияния витамина С на количество и состав лейкоцитов у темно-коричневых норок не обнаружено (Рис. 8). У сапфировых норок, имеющих морфофункциональный дефект, добавка препарата вызывала увеличение общего количества лейкоцитов периферической крови, абсолютного содержания сегментоядерных нейтрофилов и моноцитов, что подтверждает данные о роли витамина С в регуляции иммунного гомеостаза (Carcamo, Borquesz-Ojeda, Golde, 2002).
Таким образом, установлено, что у темно-коричневых и сапфировых норок наблюдается различная чувствительность к действию витамина С. Препарат вызывает стимуляцию лейкопоэза у сапфировых норок, увеличивая общее количество лейкоцитов и абсолютное содержание нейтрофилов и моноцитов – фагоцитарного звена иммунных реакций.
ВЫВОДЫ
1. В постнатальном онтогенезе у стандартных темно-коричневых, серебристо-голубых и сапфировых норок выявлены изменения уровня лейкоцитов и состава лейкоцитарной формулы. Кровь щенков норок в первые дни жизни по сравнению с последующими периодами характеризуется пониженным содержанием лейкоцитов, лимфоцитов, эозинофилов и повышенным количеством незрелых клеточных элементов (ядерные формы эритроцитов, метамиелоциты, палочкоядерные нейтрофилы). Щенки сапфировых норок по сравнению со стандартными темно-коричневыми и серебристо-голубыми отличаются более продолжительным периодом становления дефинитивного уровня содержания лейкоцитов и клеточного состава крови.
2. У сапфировых норок обнаружен дефект, выражающийся в присутствии в различных типах лейкоцитов аномально больших гранул. Нарушение субклеточной структуры лейкоцитов сапфировых норок обусловлено наличием гена алеутской окраски (а/а).
3. Дефектные гранулы нейтрофилов соответствуют лизосомам, содержащим неспецифические эстеразы – нафтол-AS-D-хлорацетат эстеразу, альфа-нафтилацетат эстеразу, а также пероксидазу и бактерицидный протеин, при отсутствии в них щелочной фосфатазы и гликогена.
4. В постнатальном онтогенезе у стандартных темно-коричневых, серебристо-голубых и сапфировых норок наблюдаются изменения активности ферментов лейкоцитов: наибольшая активность щелочной фосфатазы выявлена в 60- дневном, пероксидазы – в 120-дневном, нафтол-AS-D-хлорацетат эстеразы – в 180-дневном возрасте, тогда как наименьшая активность пероксидазы обнаружена в период раннего онтогенеза (4, 10 дней), а щелочной фосфатазы в 120- и 180-дневном возрасте.
5. У 4- и 10-дневных щенков по сравнению с 180-дневными в костном мозге отмечается повышенное содержание клеток эритроидного и гранулоцитарного ряда за исключением эозинофильных лейкоцитов. Дефект субклеточной структуры у сапфировых норок формируется в костном мозге в ходе созревания лейкоцитов и достигает максимальной степени в периферической крови. Выраженность дефекта лейкоцитов усиливается в постнатальном онтогенезе животных.
6. Витамин С увеличивает общее количество лейкоцитов и абсолютное содержание нейтрофилов и моноцитов крови у сапфировых норок и не оказывает влияние на количество и состав лейкоцитов у стандартных темно-коричневых норок.
Список использованных сокращений
НХЭ – нафтол-AS-D-хлорацетат эстераза
СЧХ – синдром Чедиак-Хигаши
ЩФ – щелочная фосфатаза
СПИСОК РАБОТ, ОПУБЛИКОВАННЫХ ПО ТЕМЕ ДИССЕРТАЦИИ
Статьи, опубликованные в ведущих рецензируемых научных журналах
1. , Голубева (Кижина) А. Г., , Тютюнник структуры лейкоцитов крови норок различных генотипов // Инфомационный вестник ВОГиС.– 2007.– Т.11, № 1.– С. 155–161.
2. Б, Голубева (Кижина) А. Г., , Тютюнник мутаций, затрагивающих окраску меха, на цитохимические особенности лейкоцитов крови у американской норки (Mustela vison Schreber, 1777) // Информационный вестник ВОГиС.– 2009.– Т. 13, № 3.– С. 571–-578.
3. Голубева (Кижина) А. Г., , Тютюнник лейкоцитов у разводимых в условиях фермы пушных зверей // Кролиководство и звероводство.– 2010.– № 4.– С. 25–27.
4. , , Илюха витамина С на морфофункциональные и цитоэнзиматические показатели крови у норок с функциональным дефектом лейкоцитов // Вопросы нормативно-правого регулирования в ветеринарии.– 2010.– № 4.– С. 216–219.
5. Б, , , , Тютюнник мутаций, затрагивающих окраску меха, на структуру лейкоцитов крови у американской норки (Mustela vison Schreber, 1777) // Генетика.– 2011.– Т. 47, № 1.– С. 87–94.
6. , , Влияние высокой дозы аскорбиновой кислоты на антиоксидантную систему и лейкоциты крови при врожденной патологии норок // Ветеринария.– 2011.–№ 8.– С. 53–57.
7. , , Ларина и цитохимические аспекта дефекта лейкоцитов в доместецируемых популяциях пушных зверей // Труды Карельского научного центра РАН.– 2011.– № 3.– С. 62–68.
Работы, опубликованные в российских и международных журналах
8. , Голубева (Кижина) А. Г., ,. Коросов особенности лейкоцитов млекопитающих, разводимых в неволе в условиях европейского севера // Труды Карельского научного центра РАН.– 2007.– Вып. 11.– С. 109–117.
9. , , , Тютюнник норки как модель в биомедицинских исследованиях // Труды Карельского научного центра РАН.– 2010.– № 2.– С. 52–61.
10. Uzenbaeva L. B., Golubeva (Kizhina) A.G., Iluha V. A., Tyutyunik N. N. and M. G. Nyuppieva. Morphometric and cytochemical investigation of subcellular structure of sapphire mink leucocytes // Scientifur.– 2007.– Vol. 31, N. 1&2.– P. 49–53.
Работы, опубликованные в сборниках трудов, материалах
региональных, российских и международных конференций
11. , , Н, Голубева (Кижина) А. Г. Особенности морфологии лейкоцитов крови у норок сапфирового окраса // Проблемы экологической физиологии пушных зверей. Петрозаводск, Карельский научный центр РАН.– 2004.–Вып. 3.– С. 46–55.
12. , Голубева (Кижина) А. Г. Активность лизосомальных протеиназ, структура и функция лейкоцитов у норок с синдромом Чедиак-Хигаши // Материалы Всероссийской конференции молодых исследователей. Санкт-Петербург, 2005. С. 98.
13. Голубева (Кижина) А. Г., , Тютюнник исследования лейкоцитов крови норок сапфирового окраса // Материалы 3-го Международного симпозиума «Физиологические основы повышения продуктивности млекопитающих, введенных в зоокультуру». Петрозаводск, 2005. С. 38–40.
14. , , Голубева (Кижина) А. Г. Морфофункциональные особенности лейкоцитов как фактор устойчивости у норок сапфирового окраса. // Материалы 3-го Международного симпозиума «Физиологические основы повышения продуктивности млекопитающих, введенных в зоокультуру». Петрозаводск, 2005. С. 214–217.
15. Голубева (Кижина) А. Г. Морфо-функциональная организация лейкоцитов норок сапфирового окраса // Материалы 10-й Пущинской школы-конференции молодых ученых «Биология – наука XXI века». Пущино, Московская область. 2006. С. 102.
16. , Голубева (Кижина) А. Г., , Нюппиева и цитохимические показатели лейкоцитов у норок различных генотипов. // Материалы 5-ой научной конференции «Инновации в науке и образовании» Калининград, 2007. Ч.1. С. 182–184.
17. , Голубева (Кижина) А. Г., , Нюппиева и цитохимические особенности лейкоцитов крови норок различных генотипов // Материалы международной научно-практической конференции, посвященной 85-летию ВНИИОЗ «Современные проблемы природопользования, охотоведения и звероводства». Киров, 2007.С. 444–445.
18. Голубева (Кижина) А. Г., Нюппиева и цитохимические особенности лейкоцитов крови у норок сапфирового окраса // Сибирский консилиум.– 2007.– № 7.– С. 31.
19. Голубева (Кижина) А. Г., Нюппиева различия активности щелочной фосфатазы в лейкоцитах крови у млекопитающих // Материалы конференции молодых сотрудников и аспирантов Института проблем экологии и эволюции им. «Актуальные проблемы экологии и эволюции в исследованиях молодых ученых». Москва, 2008. C. 101–106.
20. Голубева (Кижина) А. Г. Особенности гранулогенеза в эозинофилах костного мозга у норок различных генотипов // Материалы 15-ой школы «Актуальные проблемы биологии развития». Звенигород, 2008. C. 18-20.
21. Голубева (Кижина) А. Г., , Тютюнник нейтрофильных и эозинофильных лейкоцитов крови и костного мозга у норок различных генотипов // Материалы Международного симпозиума «Современные проблемы и методы экологической физиологии и патологии млекопитающих, введенных в зоокультуру». Петрозаводск, 2009. С.65–69.
22. , Голубева (Кижина) А. Г., , Тютюнник эозинофильных лейкоцитов крови и костного мозга у норок сапфирового окраса // Материалы Всероссийской конференции, посвященной 100-летию со дня рождения проф. «Достижения науки и практики в клеточном пушном звероводстве». Москва, 2009. С. 152–155.
23. Голубева (Кижина) А. Г., , Антюкова исследования лейкоцитов различных генотипов американской норки (Neovison vison, Schriber, 1777) // Материалы 13-й Пущинской школы-конференции молодых ученых «Биология – наука XXI века». Пущино, Московская область. 2009. С. 99.
24. Голубева (Кижина) А. Г., , Тютюнник дефект лейкоцитов у мутантов американской норки (Neovison vison, Schr.) // Материалы 5-го съезда вавиловского общества генетиков и селекционеров. Москва, 2009 г. Ч.1, С. 72.
25. Морфометрия эозинофильных и нейтрофильных гранул у норок с дефектом лейкоцитов в раннем постнатальном онтогенезе // Материалы 14-й Пущинской школы-конференции молодых ученых «Биология – наука XXI века». Пущино, Московская область. 2010. С. 136–137.
26. , , А, , , Тютюнник норки как модель для изучения синдрома Чедиак-Хигаши: особенности проявления, гранулогенез и влияние витамина С // Материалы 21-го съезда физиологического общества им. . Москва–Калуга, 2010 г. С. 249–250.
27. , , Прокопенко системы крови в раннем постнатальном онтогенезе у норок с функциональным дефектом лейкоцитов // Медицинский академический журнал.– 2010.– Т. 10, № 5. С. 121–122.
28. Kizhina A. G., Uzenbaeva L. B., Tyutyunnik N. N., Antukova E. E., Ilyukha V. V. Giant granules in bone marrow and blood leucocytes of sapphire mink // International Scientific Conference “Scientific Achievements and the Breeding Practice”. Krakow, 2010. P. 42–43.
Методическое руководство
29. , , Голубева (Кижина) А. Г. Морфо-цитохимические исследования лейкоцитов крови пушных зверей. Методические рекомендации. Петрозаводск: КарНЦ РАН, 20с.
Формат 60х84 1/16 Бумага офсетная. Гарнитура «Times».
Уч.–изд. л. 1,0. Усл. печ. л. 1,1. Подписано в печать 14.10.2011
Тираж 100 экз. Изд. № 000. Заказ № 000.
Карельский научный центр РАН
Редакционно–издательский отдел
Петрозаводск, пр. А. Невского, 50









